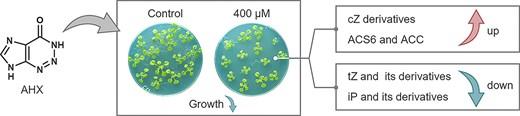

研究業績
Biosci. Biotechnol. Biochem. 90, 27–36 (2025)
Comprehensive transcriptomic analysis revealing that 2-azahypoxanthine treatment induces the stress response in Arabidopsis thaliana
著者
Tanaka, Y., Suzuki, T., Mitsukuni, K., Choi, J-H., Nomura, T., Xie, X., Kojima, M., Takebayashi, Y., Sakakibara, H., Ouchi, H., Inai, M., Dohra, H., Okamoto, M., and Kawagishi, H.
カテゴリ
学術論文